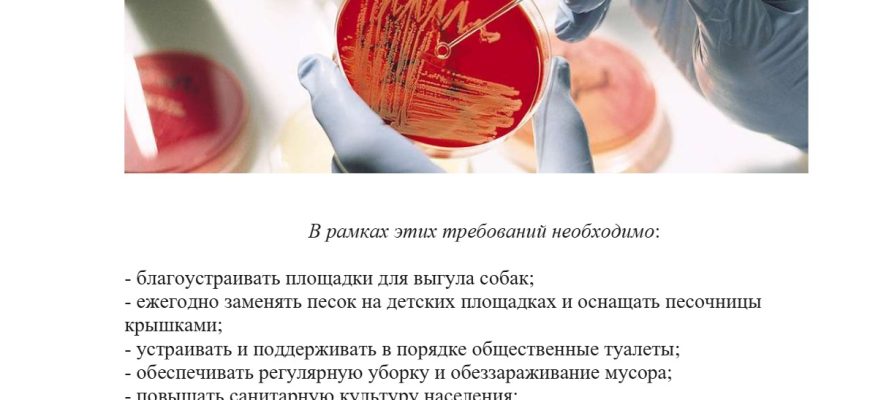

Блог
Весна — время пробуждения природы, появления тепла и первых цветов. Однако, с приходом весны наступает и время активности различных вредителей, которые
Весна — прекрасное время для оживления природы, однако она также может сопровождаться проблемами с вредителями. Одни из них возвращаются из зимней
Лето – прекрасное время для проведения различных мероприятий на свежем воздухе. Но, к сожалению, в это же время активизируются различные насекомые: комары
Весна — это время обновления и обновления. С наступлением первых теплых дней мы начинаем задумываться о перестановке мебели, уборке и проветривании нашего дома.
Весна приносит с собой не только пробуждение природы и расцвет цветов, но и неприятное явление – весеннее нашествие насекомых. Мухи, москиты, тараканы
С приходом весны многие любители садоводства и огородники готовятся к новому сезону и заботятся о своих растениях. И одной из главных задач весенней профилактики
Весна – время пробуждения природы и обновления вокруг нас. Однако вместе с приходом теплых дней и солнечных лучей у нас появляется еще одна проблема –
Весна – время, когда природа просыпается от зимней спячки, цветы начинают распускаться, а птицы весело щебечут на ветках деревьев. Однако, весна также
С наступлением весны владельцы недвижимости и управляющие компании сталкиваются с новыми вызовами — появлением вредителей, которые угрожают не только
Весна – прекрасное время года, когда природа пробуждается, и мы с радостью приветствуем тепло и солнце. Однако весна также приносит с собой нашествие насекомых